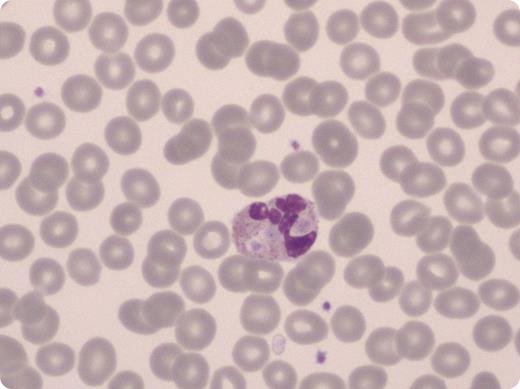
A 96-year-old woman with a past medical history of hypertension, medication noncompliance, and lack of medical follow-up was brought to the emergency room with altered mental status. She was to found to have malignant hypertension with concomitant acute pontine hemorrhage. Her hemoglobin level, hematocrit level, and platelet count were normal. Her white blood cell count was elevated, at 17 200 mcL. Peripheral smear showed leukocytosis with neutrophil predominance. Several neutrophils were noted to have phagocytosed platelets. EDTA-dependent platelet phagocytosis has been previously reported in a young man whose platelet count was 35 000 mcL when collected in EDTA but was normal when collected in sodium citrate or heparin. Although this patient's platelet count was normal, pseudothrombocytopenia can have multiple causes, including platelet clumping, platelet satellitosis of neutrophils, and rarely, platelet phagocytosis. Such phenomena may be induced or enhanced by the anticoagulant EDTA, through the action of EDTA-dependent autoantibodies. / The literature is mixed as to whether EDTA-dependent platelet phenomena occur more frequently in ill or hospitalized patients compared with in healthy control patients. Clinicians should carefully review the peripheral smear when consulted to evaluate a new case of thrombocytopenia. Pseudothrombocytopenia from any cause may lead to extensive and unnecessary workup for thrombocytopenia. Awareness of such phenomena can prevent errors such as delaying surgery, holding medications, or giving unneeded platelet transfusion for purported thrombocytopenia.

A 96-year-old woman with a past medical history of hypertension, medication noncompliance, and lack of medical follow-up was brought to the emergency room with altered mental status. She was to found to have malignant hypertension with concomitant acute pontine hemorrhage. Her hemoglobin level, hematocrit level, and platelet count were normal. Her white blood cell count was elevated, at 17 200 mcL. Peripheral smear showed leukocytosis with neutrophil predominance. Several neutrophils were noted to have phagocytosed platelets. EDTA-dependent platelet phagocytosis has been previously reported in a young man whose platelet count was 35 000 mcL when collected in EDTA but was normal when collected in sodium citrate or heparin. Although this patient's platelet count was normal, pseudothrombocytopenia can have multiple causes, including platelet clumping, platelet satellitosis of neutrophils, and rarely, platelet phagocytosis. Such phenomena may be induced or enhanced by the anticoagulant EDTA, through the action of EDTA-dependent autoantibodies.
The literature is mixed as to whether EDTA-dependent platelet phenomena occur more frequently in ill or hospitalized patients compared with in healthy control patients. Clinicians should carefully review the peripheral smear when consulted to evaluate a new case of thrombocytopenia. Pseudothrombocytopenia from any cause may lead to extensive and unnecessary workup for thrombocytopenia. Awareness of such phenomena can prevent errors such as delaying surgery, holding medications, or giving unneeded platelet transfusion for purported thrombocytopenia.
A 96-year-old woman with a past medical history of hypertension, medication noncompliance, and lack of medical follow-up was brought to the emergency room with altered mental status. She was to found to have malignant hypertension with concomitant acute pontine hemorrhage. Her hemoglobin level, hematocrit level, and platelet count were normal. Her white blood cell count was elevated, at 17 200 mcL. Peripheral smear showed leukocytosis with neutrophil predominance. Several neutrophils were noted to have phagocytosed platelets. EDTA-dependent platelet phagocytosis has been previously reported in a young man whose platelet count was 35 000 mcL when collected in EDTA but was normal when collected in sodium citrate or heparin. Although this patient's platelet count was normal, pseudothrombocytopenia can have multiple causes, including platelet clumping, platelet satellitosis of neutrophils, and rarely, platelet phagocytosis. Such phenomena may be induced or enhanced by the anticoagulant EDTA, through the action of EDTA-dependent autoantibodies.
The literature is mixed as to whether EDTA-dependent platelet phenomena occur more frequently in ill or hospitalized patients compared with in healthy control patients. Clinicians should carefully review the peripheral smear when consulted to evaluate a new case of thrombocytopenia. Pseudothrombocytopenia from any cause may lead to extensive and unnecessary workup for thrombocytopenia. Awareness of such phenomena can prevent errors such as delaying surgery, holding medications, or giving unneeded platelet transfusion for purported thrombocytopenia.
For additional images, visit the ASH IMAGE BANK, a reference and teaching tool that is continually updated with new atlas and case study images. For more information visit http://imagebank.hematology.org.
This feature is available to Subscribers Only
Sign In or Create an Account Close Modal